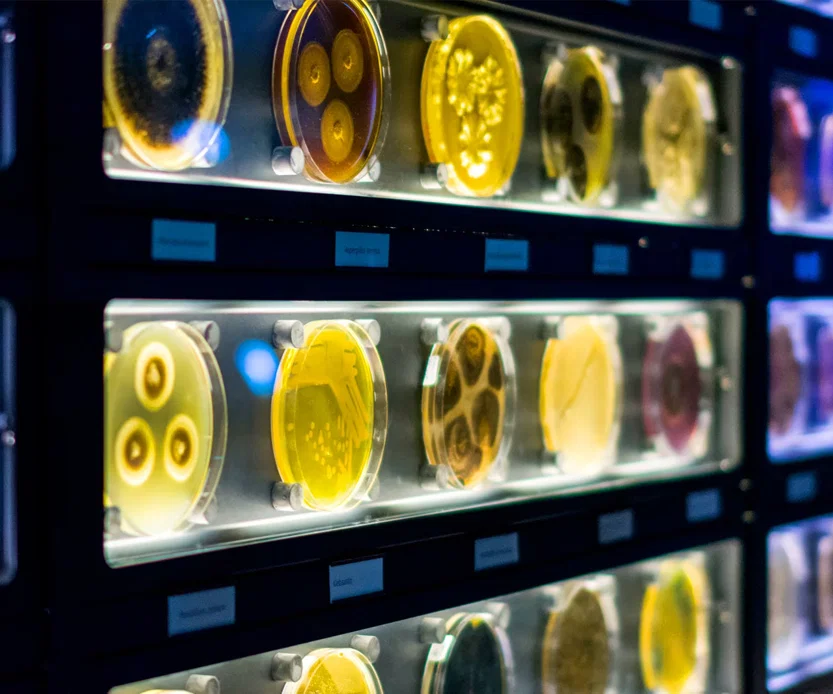
מיקרובים חיים בתוך צלחות פטרי ומבחנות - בתצוגה של גן החיות

בעוד שגני חיות מסורתיים מציגים פילים וג’ירפות, מוזיאון המיקרובים הראשון בעולם, שהוקם בהשקעה של כ־10 מיליון אירו לצד גן החיות המלכותי “ארטיס” באמסטרדם, מציג את ה“מיקרו־טבע”. לפי מנהל המקום, האיג באליאן, חשיבותם של המיקרובים הוזנחה במשך שנים רבות, אף שהם חיוניים לייצור דלק ביולוגי, לפיתוח אנטיביוטיקה ולשיפור היבולים החקלאיים.
המוזיאון עצמו מעוצב כמעבדה עתידנית, המוארת כמעט רק באמצעות המוצגים עצמם, מה שמעניק למבקרים תחושה של מסע אל הלא־נודע. במקום לצפות במיקרובים בלבד דרך מיקרוסקופים המחוברים למסכי ענק, המבקרים גם משתתפים בניסויים חיים.
בין המוצגים הבולטים נמצא ה־Kiss-o-Meter – מכשיר שמודד את כמות החיידקים העוברת בין שני אנשים בזמן נשיקה, למי שמעז לבדוק. לצדו מוצג סורק גוף אינטראקטיבי המדגים אילו יצורים מיקרוסקופיים חיים על גופו של המבקר ובאילו אזורים הם מרוכזים. בנוסף, תצוגת הריסים מציעה זום־אין מרשים במיוחד אל עולם קרדיות האבק החיות על ריסי העיניים של כולנו – ולעיתים אף חושפת את המיקרואורגניזמים הנלווים להן.
מעבדה חיה בלב המוזיאון
בניגוד למוזיאונים רגילים, במיקרוביה פועלת מעבדה אמיתית שבה טכנאים מטפלים ביותר מ-40 מינים של מיקרובים חיים בתוך צלחות פטרי ומבחנות. הטכנאים משמשים גם כ"מטפלים בגן החיות" וגם כמדריכים, ועונים על שאלות הקהל לגבי היצורים הזעירים שמרכיבים כ-1.5 קילוגרם ממשקל גופו של כל אדם מבוגר.
"ביקור כאן ישנה לעד את הדרך שבה אנשים רואים את העולם," מסכם באליאן. המטרה היא להוציא את המיקרוביולוגיה מהמעבדות הסגורות אל הציבור הרחב, ולהראות כיצד הכל בטבע קשור זה בזה דרך היצורים הקטנים ביותר.







0 תגובות